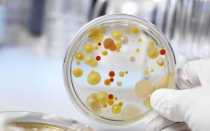
Что такое стрептококковая инфекция в урологии

Стоматологическая клиника
Россия, Ставрополь, Комсомольская
Телефон:
+7 (865) 221-55-
+7 (865) 221-55-
Пн-сб: 09:00—20:00
Свежие публикации
Показать ещё